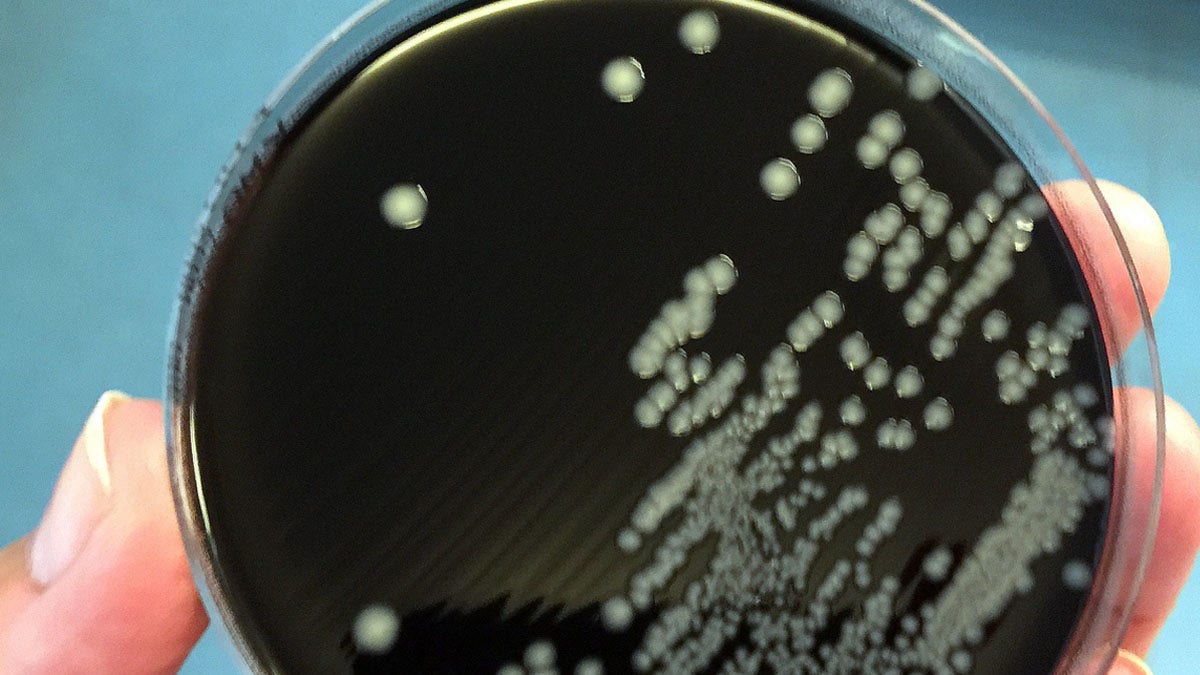
Campylobacter

The McDonald’s E. coli outbreak — which has now sickened more than 100 people, per reports — has spotlighted the risk of foodborne illnesses.
The E. coli infections were linked to contaminated onions served on McDonald’s Quarter Pounder hamburgers, according to the U.S. Centers for Disease and Prevention (CDC), which continues to investigate the outbreak.
Many other foods could potentially transmit dangerous bacteria if stored or prepared in an unsafe manner, experts say, with an estimated 48 million people (one in six) affected each year, per the CDC.
E. COLI OUTBREAK LINKED TO MCDONALD’S BURGERS: HOW TO SPOT THE SYMPTOMS
Fox News Digital spoke with food safety experts about some of the most prevalent foodborne illnesses and how to prevent them.
1. E. coli
E. coli — officially known as Escherichia coli — is a type of bacterium found in the environment, foods and intestines of people and animals, according to the CDC.

E. coli — officially known as Escherichia coli — is a type of bacterium found in the environment, foods and intestines of people and animals. (iStock)
The bacterium can spread via contaminated food or water or contact with animals, environments or other people, the same source stated.
Eating meat that has not been cooked sufficiently to kill E. coli can cause infection, according to Mitzi D. Baum, CEO of Stop Foodborne Illness in Chicago.
SUPERBUGS DUE TO ANTIBIOTIC RESISTANCE COULD KILL 39 MILLION PEOPLE BY 2050, LARGE STUDY FINDS
“Among other known sources of infection is consumption of sprouts, lettuce, salami, unpasteurized milk (and milk products) and unpasteurized juice, and swimming in or drinking sewage-contaminated water,” she told Fox News Digital.
“Bacteria in the diarrheal stools of infected persons can be passed from one person to another if hygiene or handwashing habits are inadequate,” Baum added.
Symptoms and treatment
Symptoms of E. coli illness include — but are not limited to — severe stomach cramps, diarrhea (often bloody), vomiting, respiratory illness, urinary tract infections, fever and pneumonia, according to the CDC.
E. coli can become “dangerous or deadly” in very young people, older adults and those with compromised immune systems, who may develop a condition called hemolytic uremic syndrome (HUS), according to Baum.

Symptoms of E. coli illness may include severe stomach cramps, diarrhea (often bloody), vomiting, respiratory illness, urinary tract infections, fever and pneumonia. (iStock)
Symptoms of HUS may include fever, abdominal pain, pale skin tone, fatigue, irritability, decreased urination, swelling, and small, unexplained bruises or bleeding from the nose and mouth, the expert added.
“Non-specific supportive therapy, including hydration, is important,” Baum said.
E. coli can become “dangerous or deadly” in very young people, older adults and those with compromised immune systems.
“There is no evidence that treatment with antibiotics is helpful, and taking antibiotics may increase the risk of HUS.”
Treatment often consists of supportive care, Baum said, with close monitoring of kidney (renal) functioning, hemoglobin and platelet counts.
2. Listeria
Listeria is the third-leading cause of death from foodborne illness in the country, according to the CDC.
The bacterium is known to spread easily in delis and in environments where food is prepared.

The Listeria bacterium is known to spread easily in delis and in environments where food is prepared. (iStock)
“The bacterium has been found in a variety of raw foods, such as uncooked meats and vegetables, as well as in foods that become contaminated after cooking or processing, such as soft cheeses, smoked seafood, and processed meats such as hot dogs and deli meat,” Baum said.
“Unpasteurized (raw) milk and cheeses and other foods made from unpasteurized milk are particularly likely to contain the bacterium.”
LISTERIA INFECTION LINKED TO DELI MEATS KILLS 2, INFECTS 28 ACROSS US, CDC WARNS
Listeria is killed by pasteurization and cooking, Baum noted, but some ready-to-eat foods may become contaminated before packaging.
“Unlike most bacteria, Listeria can grow and multiply in some foods in the refrigerator,” she warned.
Symptoms and treatment
The most common symptoms of listeria infection include fever, fatigue and muscle aches, per the CDC.
“Someone with listeriosis usually has fever and muscle aches, which are sometimes preceded by diarrhea or other gastrointestinal symptoms,” Baum said.
“Almost everyone diagnosed with listeriosis has an ‘invasive’ infection where the bacterium spreads beyond the GI tract.”

Listeria is the third-leading cause of death from foodborne illness in the country, according to the CDC. (BSIP/UIG Via Getty Images)
Some people also experience stiff neck, headaches, balance problems, seizures or disorientation.
Listeriosis is treated with antibiotics.
“A person in a high-risk category who experiences fever and other non-specific symptoms, such as fatigue and aches, within two months of eating contaminated food should seek medical care,” Baum advised.
3. Norovirus
Norovirus is a highly contagious virus that causes inflammation of the stomach or intestines, per the CDC.
NOROVIRUS ALERT: FDA WARNS OF CONTAMINATED RAW OYSTERS FROM MEXICO
“Norovirus, also known as Norwalk-like virus, is a leading cause of gastroenteritis in the U.S.,” Dr. Amber Charoen, a board-certified gastroenterologist with Gastro Health in Kennewick, Washington, told Fox News Digital.
“It can spread with as few as 10 particles through contaminated food, vomit, stool and even person-to-person contact.”
Symptoms and treatment
While it is often referred to as a “stomach flu” or “stomach bug,” norovirus is not related to influenza.
“Symptoms of norovirus vary, but those infected tend to have a mix of low-grade fever, chills, vomiting, headache, muscle aches and fatigue,” Baum said.

Norovirus is a highly contagious virus that causes inflammation of the stomach or intestines, per the CDC. (iStock)
“In addition, norovirus outbreaks typically produce nausea (more often in children), watery diarrhea (more often in adults) and stomach cramps.”
There is no specific medicine to treat norovirus, according to Baum.
“If you have norovirus illness, drink plenty of liquids to replace fluids lost from throwing up and diarrhea,” she advised.
4. Salmonella
Salmonella is a bacterium that is often linked to poultry, eggs, dairy and other foods like fresh produce, meats and nuts, according to Charoen.
Infections can be caused by consuming contaminated chicken, pork, fruits, seeded vegetables, other produce, beef and turkey, the CDC states on its website. Germs can spread to other foods through cross-contamination.

Salmonella is a bacterium that is often linked to poultry, eggs, dairy and other foods like fresh produce, meats and nuts. (iStock)
Symptoms and treatment
Most people who are infected experience diarrhea, stomach cramps and fever, according to the CDC. Headaches, vomiting and nausea can also occur.
Most patients notice symptoms within six hours to six days after getting infected, and they usually last for four to seven days.
SALMONELLA OUTBREAK CAUSED BY TINY TURTLES, CDC WARNS, WITH CASES ACROSS 21 STATES
“Most people recover without specific treatment,” Baum said. “Antibiotics are typically used only to treat people with severe illness.”
Patients should drink extra fluids as long as diarrhea is occurring, she advised.
5. Campylobacter
Campylobacteriosis is a bacterium most often associated with eating raw or undercooked poultry or from cross-contamination of other foods by these items, according to Baum.
Campylobacteriosis is a bacterium most often associated with eating raw or undercooked poultry or from cross-contamination of other foods. (iStock)
“Many chicken flocks are infected with Campylobacter but show no signs of illness,” she noted.
“Campylobacter can easily spread from bird to bird through a common water source or through contact with infected feces.”
Symptoms and treatment
Typical symptoms of Campylobacteriosis illness include diarrhea, cramping, abdominal pain and fever.
“Diarrhea caused by this infection can be either watery or bloody, depending on the area of the intestines affected, and typically begins two to five days after exposure,” said Charoen.
In addition to gastrointestinal symptoms, Campylobacter infection has also been linked to long-term issues like reactive arthritis and Guillain-Barré syndrome, which can affect the joints and nervous system, Charoen added.
TUBERCULOSIS HAS OVERTAKEN COVID AS WORLD’S DEADLIEST INFECTIOUS DISEASE
Almost all people infected with Campylobacter recover without any specific treatment, according to Baum.
“Patients should drink extra fluids as long as the diarrhea lasts,” she advised.
“In more severe cases, antibiotics such as azithromycin or erythromycin can shorten the duration of symptoms if given early in the illness.”

Typical symptoms of Campylobacteriosis illness include diarrhea, cramping, abdominal pain and fever. (iStock)
Beyond the five listed above, there are other bacteria that can cause foodborne illness.
These include Staphylococcus aureus (Staph), Clostridium perfringens, toxoplasma and others.
Preventing foodborne illness
Dr. Benjamin Barlow, an emergency physician and chief medical officer of American Family Care — a provider of urgent care, accessible primary care and occupational medicine in Alabama — provided the following guidance for preventing contamination of foods.
CLICK HERE TO GET THE FOX NEWS APP
“You can prevent foodborne illnesses by washing your hands after touching any animals or their food, or being in their environment,” Barlow, the former senior White House physician for Presidents Obama and Trump, told Fox News Digital.
“Avoid eating any undercooked food such as ground beef, poultry or eggs and raw/unpasteurized milk, including cheeses made with it,” he added.

Experts say to wash any fruits and vegetables before cooking and to keep raw meat separate from other foods. (iStock)
Before beginning food prep, wash your hands for 20 seconds with soap and water, Barlow advises.
“Also, wash your hands between touching raw meats and other food before eating,” he said. “If you can, wear gloves while preparing food.”
It’s also best practice to wash any fruits and vegetables before cooking and to keep raw meat separate from other foods.
CLICK HERE TO SIGN UP FOR OUR HEALTH NEWSLETTER
When cooking food, use a thermometer to make sure it reaches the safe minimum internal temperature, Barlow emphasized.
Safe temperatures are 165°F for chicken and 145°F for beef, pork and shellfish.
Safe temperatures are 165°F for chicken and 145°F for beef, pork and shellfish.
It’s also important to check expiration dates and discard expired items, experts agree.
“Make sure food is refrigerated within two hours of being cooked – this is especially important as we enter the season of holiday parties,” Barlow said.
For more Health articles, visit www.foxnews.com/health
“In the summer heat, food should be refrigerated after one hour.”
Anyone experiencing any gastrointestinal symptoms, such as diarrhea or vomiting, should not prepare any food to avoid passing on the bacterium or virus, the doctor added.









